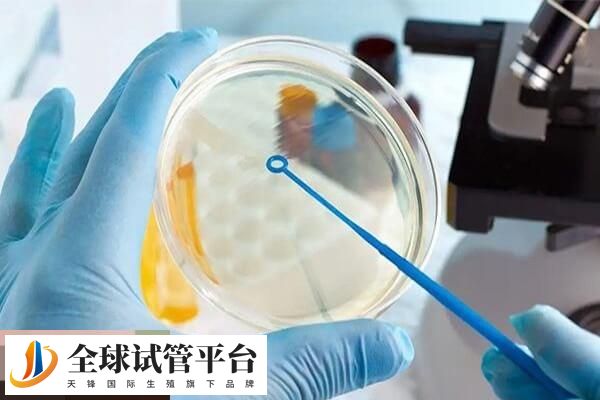
不同年龄试管成功率不同

针对试管婴儿多次移植失败的情况,建议患者首先要查明原因,这样可以根据具体症状进行对症治疗。如果患者是因为宫颈炎、免疫异常或凝血功能障碍导致多次失败,应及时前往医院进行治疗后再移植。如果患者是因为宫腔病症导致移植失败,可通过手术治疗后进行移植,以此可提高下一次移植的成功率。

试管婴儿反复移植失败的原因
试管婴儿技术是一项重大的医疗进步,它可以帮助那些无法自然受孕的夫妇实现生育梦想,但是试管婴儿的成功率并不是百分之百的,并且在一些情况下,反复尝试也可能会失败。至于失败的原因都有哪些,如下所示:
1、年龄问题
女性的年龄是影响试管婴儿成功率的因素之一。女性随着年龄的增加,生育能力会逐渐下降,并且伴随着潜在的遗传疾病风险。因此,性年龄越大,移植成功的机会就越小。
2、受孕历史
受孕历史也是一个重要的因素。如果一个女性之前可以自然怀孕生育孩子,那么她的身体状况可能更加健康,而且她的生育能力也可能对试管移植的失败造成一定的影响。
3、生殖系统疾病或妇科手术史
如果女性之前有过生殖系统疾病,或者接受过妇科手术,如子宫纤维瘤切除等,可能会影响移植成功率。这些疾病或手术可能会对子宫内膜质量和形态产生不利的影响。
4、免疫系统和遗传因素
某些自身免疫疾病,如类风湿性关节炎和系统性红斑狼疮等,可能会影响移植的成功率。同时,一些遗传因素也可能会影响试管婴儿的成功率。
试管反复移植失败该怎么办
试管婴儿反复移植失败可能会给夫妇带来极大的心理和生理压力,但是还有许多解决办法。以下是一些可行的解决方案
- 1、进一步检查:如果尝试多次试管婴儿移植程序失败的话,可以考虑进行进一步检查。这些测试可能包括不育原因的全面评估、子宫内膜质量评估、卵子和精子质量评估等。
- 2、可重复操作性:试管婴儿手术是一项心理和身体上都具有压力的过程。考虑通过减少移植的次数和补充体内的营养和荷尔蒙等,以增加反复移植的成功率。
- 3、选择更好的诊所和医生:选择一家更专业、更有经验的试管婴儿诊所和医生,是增加试管婴儿移植成功率的一个有效方法。
- 4、改变生活方式:改变生活方式可以促进健康的生育环境。建议减少烟酒、保持清淡饮食、加强锻炼等,以提高身体的免疫力和增强生育能力。
- 5、其他选择:如果试管婴儿移植一直反复失败,可以考虑其他的不孕不育解决方案。






